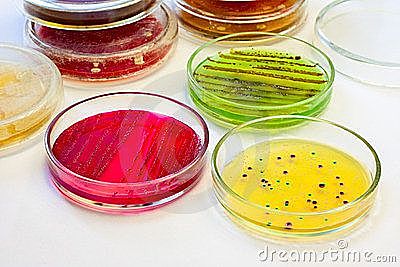
INVENCIÓN DE LAS PLACAS PETRI.

-
Un progreso tecnológico, el microscopio, permitió la observación de unos “bichos diminutos”, de un mundo desconocido presente allí donde se mirara: aguas, suelos, cuerpos de animales, plantas, el propio organismo humano. Pero esta presencia “universal” no produjo ningún avance intelectual además del propio conocimiento derivado de la observación. Era un mundo nuevo e “invisible” que no tenía ningún papel aparente. Este pensamiento perduró desde la mitad del XVII hasta la mitad del XIX.
-
Robert Hook (1635-1703) publica su libro: Micrographia, dedicado a las observaciones microscópicas,donde ilustro los cuerpos fructiferantes de los mohos, ademas de otras descripciones biológicas,como la famosa primera observación de las celdas (cells) en la rodaja de corcho,lo que marco el comienzo de la teoría celular.
-
Antoni Van Leevhenhoek (1632-1723) fue el primero en observar a través de un microscopio simple de una lente éstas células microbianas a las que llamo "diminutos animálculos".
-
Van Leeuwenhoek informó sus investigaciones en una serie de cartas a la prestigiosa Royal Society de Londres, quien las publicó en inglés.
-
El medico Ignaz Semmelweis propuso el lavado de manos para intentar controlar las infecciones hospitalarias, ya que descubrió que la incidencia de la sepsis puerperal o fiebre puerperal (también conocida como «fiebre del parto») podía ser disminuida drásticamente usando desinfección de las manos en las clínicas obstétricas.
-
Louis Pasteur (1822-1895) demostró que los procesos fermentativos son consecuencia de la actividad microbiana.
Estudio la fermentación alcohólica y concluyó que estaba catalizada por microorganismos vivos: las células de levadura, las cuales convierten los azucares en alcohol. -
Louis Pasteur relacionó a el crecimiento bacteriano con el deterioro de las bebidas alcohólicas, como la cerveza y el vino, lo que lo llevo a idear el proceso de Pausterizacion, en el cual se aplican altas temperaturas por un corto intervalo de tiempo con el fin de eliminar dichas bacterias. Este tratamiento luego se adaptó a la conservación de la leche y otros alimentos.
-
A través de una serie de experimentos proporcionó evidencia de que los microorganismos no pueden originarse espontáneamente a partir de materia inerte. Toda aparición de vida “espontanea” (contaminación) en soluciones estériles puede atribuirse a microorganismo que ya estaban presentes en el aire, o en el líquido mismo.Ademas, demostró que la vida microbiana puede ser destruida por calor.
-
Joseph Lister (1827-1912) fue un medico británico que introdujo técnicas de asepsia en la cirugía usando diluciones de fenol, logrando reducir considerablemente la mortalidad por infecciones bacterianas. .
-
Ferdinand Cohn (1828-1898) descubrió la formación de endosporas por parte de algunas bacterias.
Ademas describió el ciclo vital de la bacteria formadora de Basillus, sentó las bases de un sistema de clasificación bacteriana.e ideo varios métodos eficaces para prevenir la contaminación de los medios de cultivos. -
Robert Koch (1843-1910) fue el primero en demostrar, a través de su investigación del carbunco (enfermedad causada por el basillus antharacis) que las bacterias pueden actuar como agentes específicos en la producción de enfermedades infecciosas. Con base en esos estudios formuló los postulados de Koch.
Además, mediante la técnica de cultivo puro,logro el aislamiento y propagación in vitro del bacilo, e introdujo el uso de medios de cultivos sólidos o semisólidos como el agar. -
La importancia de los microorganismos como causantes de las enfermedades infecciosas no fue bien conocida hasta el siglo xix. tradicionalmente se creía que las enfermedades eran consecuencia de fuerzas sobrenaturales, o del desequilibrio entre los cuatro humores del cuerpo humano (sangre, flema, bilis amarilla [cólera] y bilis negra [melancolía]).
-
Koch descubre el agente causante de la tuberculosis, la bacteria Mycobacterium tuberculosis.
-
Administración de la primera vacuna contra la rabia a un ser humano, elaborada por Pasteur.
-
Richard Petri inventó las placas transparentes de dos caras conocidas como placas Petri, una herramienta estándar para la obtención de cultivos puros.
-
Sergei Winogradsky(1856-1953) descubrió el proceso de fijación del nitrógeno y fue el primero en aislar y describir a las bacterias nitrificantes y a las fijadoras de nitrógeno, como el anaerobio Clostridium pasteurianum,además demostró que estas catalizan transformaciones químicas especificas del naturaleza y propuso el concepto de quimiolitotrofía: la oxidación de compuestos inorgánicos para obtener energía, revelando así la importancia de los microorganismos en los procesos geoquimicos.
-
El objetivo de la ecología microbiana es estudiar el papel de los microorganismos en la naturaleza y las relaciones existentes entre los microorganismos y otros seres vivos y el ambiente
-
Martinus Beijerinck describió por primera vez un virus, a través de sus estudios de la enfermedad del mosaico de tabaco, y demostró que este agente infeccioso era mas pequeño que una bacteria y se incorporaba a las células de la planta hospedadora viva.
-
Martinus Beijerinck (1851-1931) formulo la técnica del cultivo de enriquecimiento. Por esta técnica los microorganismos se aíslan de muestras naturales de un modo muy selectivo mediante la manipulación de las condiciones nutricionales y de incubación. Esto permitió el cultivo de una gran variedad de microorganismos que hasta ese momento no habían podido ser aislados.,como las bacterias reductoras de sulfato y oxidantes de azufre, las del ácido láctico, las algas verdes, bacterias anaerobias, etc
-
El conjunto de trabajos desarrollados en las diferentes edades de la microbiología, en especial a partir de la edad patológica, fueron la base de los impresionantes logros alcanzados durante el siglo XX. En el cual se desarrollaron nuevas subdisciplinas básicas y aplicadas de la microbiologia, como la inmunologia,virología bacteriología, micologia y parasitologia,
-
A mediados del siglo XX, a partir de los estudios sobre las propiedades genéticas de los microorganismos se desarrollaron nuevos campos de la biología molecular, la ingenieria genética y la genómica.
Plan projects on a visual timeline
Map milestones, phases, deadlines, and key events in one place so the sequence is easier to see and share. Timetoast is a timeline maker for work, school, research, and stories.